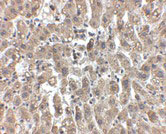

> Antigen, Antibodies, ELISA, Western Blot > Primary Antibody > Polyclonal Antibodies > LDL-R AntibodyBrand |
Leading Biology | Catalog Number |
APR08182G |
Product Type |
Polyclonal Antibodies | Field of Research |
|
Product Overview |
We constantly strive to ensure we provide our customers with the best antibodies. As a result of this work we offer this antibody in purified format.
We are in the process of updating our datasheets. If you have any questions regarding this update, please feel free to contact our technical support team.
This product is a high quality LDL-R antibody.
|
||
Molecular Weight |
95376 Da
|
||
Cellular Localization |
Antigen Cellular Localization:
Cell membrane; Single-pass type I membrane protein. Endomembrane system; Single-pass type I membrane protein Membrane, clathrin-coated pit; Single-pass type I membrane protein. Golgi apparatus. Early endosome. Late endosome. Cell surface. Lysosome. Note=Found distributed from the plasma membrane to intracellular compartments. Localizes to the Golgi apparatus, early and late endosomes/lysosomes and cell surface in the presence of PCSK9
|
||
Host |
Chicken
|
||
Species Reactivity |
Human, Mouse, Rat
|
||
Target |
LDLR;
|
||
Isotype |
IgY
|
||
GeneID |
|||
UniProt ID |
|||
Function |
Binds LDL, the major cholesterol-carrying lipoprotein of plasma, and transports it into cells by endocytosis. In order to be internalized, the receptor-ligand complexes must first cluster into clathrin-coated pits. In case of HIV-1 infection, functions as a receptor for extracellular Tat in neurons, mediating its internalization in uninfected cells.
|
||
Summary |
LDL-R Antibody: The low density lipoprotein receptor (LDL-R) gene family consists of cell surface proteins involved in receptor-mediated endocytosis of specific ligands. Low density lipoprotein (LDL) is normally bound at the cell membrane and taken into the cell ending up in lysosomes where the protein is degraded and the cholesterol is made available for repression of microsomal enzyme 3-hydroxy-3-methylglutaryl coenzyme A (HMG CoA) reductase, the rate-limiting step in cholesterol synthesis. At the same time, a reciprocal stimulation of cholesterol ester synthesis takes place. Mutations in the LDL-R gene cause the autosomal dominant disorder, familial hypercholesterolemia. Along with SCARB1, CLDN1, and the tetraspanin superfamily member CD81, LDL-R has been reported to be an entry factor for the Hepatitis C virus. At least three isoforms of LDL-R are known to exist.
|
||
Form |
Liquid |
||
Storage & Stability |
Store at +4°C short term. For long-term storage, aliquot and store at -20°C or below. Stable for 12 months at -20°C. Avoid repeated freeze-thaw cycles.
|
||
Applications |
WB, IHC-P, IF, E
|
||
Images |

Western blot analysis of LDL-R in human liver tissue lysate with LDL-R antibody at (A) 1 and (B) 2 μg/mL.
Immunohistochemistry of LDL-R in human liver tissue with LDL-R antibody at 2.5 μg/mL. 
Immunofluorescence of LDLR in human liver tissue with LDLR antibody at 20 μg/mL. |
||
Specification |
|||
Quantity |
|
||
| Select | Brand | Catalog No. | Product Name | Pack Size | Type | Field of Research | Specification | Quantity | Price(USD) | |
| 1 | Leading Biology | APR03440G | ITGA11 Antibody (N-term) | 100 μl | Polyclonal Antibodies |
|
$495.00 | Add Ask | ||
| 2 | Leading Biology | APR04537G | CMIP Antibody (C-term) | 100 μl | Polyclonal Antibodies |
|
$495.00 | Add Ask | ||
| 3 | Leading Biology | APR12422G | Human H4 Histamine Receptor (extracellular) Antibody | 50 μl | Polyclonal Antibodies |
|
$695.00 | Add Ask | ||
| 4 | Leading Biology | APR03844G | UBE2W Antibody (C-term) | 100 μl | Polyclonal Antibodies |
|
$495.00 | Add Ask | ||
| 5 | Leading Biology | APR04349G | HECTD2 Antibody (N-term) | 100 μl | Polyclonal Antibodies |
|
$495.00 | Add Ask | ||
| 6 | Leading Biology | APR03502G | IGHG1 Antibody (Center) | 100 μl | Polyclonal Antibodies |
|
$495.00 | Add Ask |
 Leading Biology Inc.
2600 Hilltop DR, Building G, B Suite C138
Richmond, CA, 94806
Tel: 1-661-524(LBI)-0262
Email: info@leadingbiology.com
Leading Biology Inc.
2600 Hilltop DR, Building G, B Suite C138
Richmond, CA, 94806
Tel: 1-661-524(LBI)-0262
Email: info@leadingbiology.com
Complete this form and click send to ask us a question, request a quote or simply say hello.

You have 0 item in your cart

You have 0 item in your inquiry list
